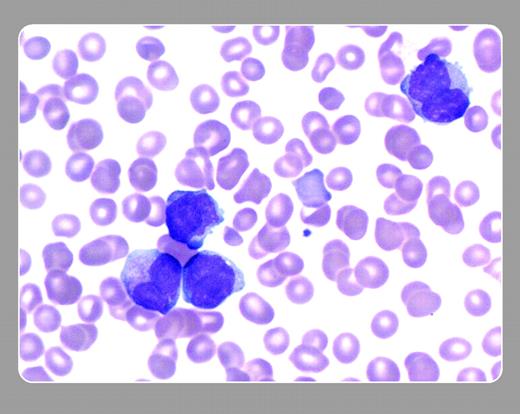
John J. Lazarchick, Department of Pathology, Mobile Infirmary, and John Lazarchick, Department of Pathology, Medical University of South Carolina

Peripheral smear from a 22-year-old male with a white blood cell count (WBC) of 18.5 × 109/L. Abnormal promyelocytes with bilobate nuclei with conspicuous nucleoli are evident. Partial overlapping lobes are most evident in the cell at the top right. Numerous small azurophilic granules are present in the cytoplasm of the cell at the lower left. All of the cells stained strongly positive with myeloperoxidase and showed the t(15:17) translocation on fluorescent in situ hybridization (FISH) analysis. The WBC in the microgranular variant is typically increased as opposed to low or normal WBCs seen in hypergranular acute promyelocytic leukemia.FIG1
 John J. Lazarchick, Department of Pathology, Mobile Infirmary, and John Lazarchick, Department of Pathology, Medical University of South Carolina
John J. Lazarchick, Department of Pathology, Mobile Infirmary, and John Lazarchick, Department of Pathology, Medical University of South Carolina
 John J. Lazarchick, Department of Pathology, Mobile Infirmary, and John Lazarchick, Department of Pathology, Medical University of South Carolina
John J. Lazarchick, Department of Pathology, Mobile Infirmary, and John Lazarchick, Department of Pathology, Medical University of South Carolina
Many Blood Work images are provided by the ASH IMAGE BANK, a reference and teaching tool that is continually updated with new atlas images and images of case studies. For more information or to contribute to the Image Bank, visit www.ashimagebank.org.